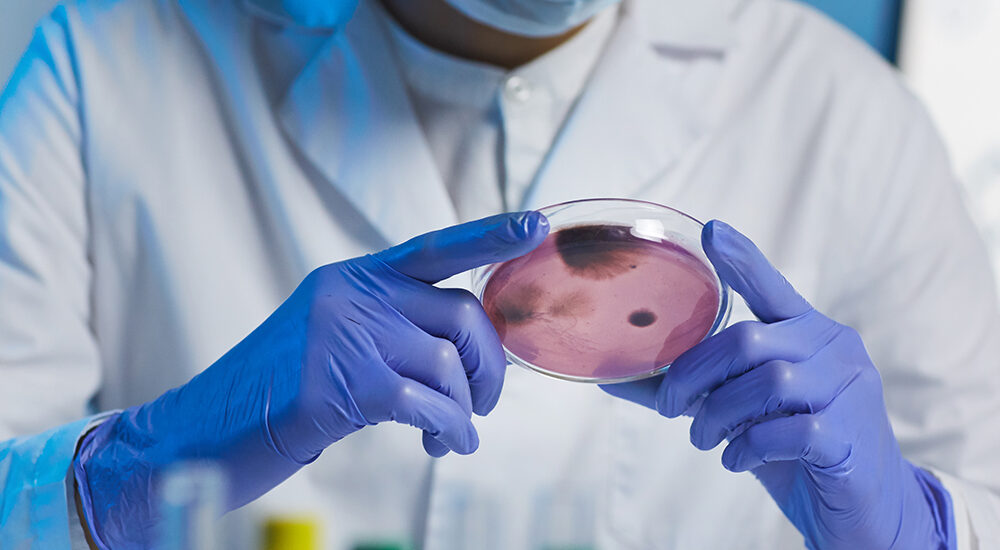
Komórki macierzyste w chirurgii plastycznej – przyszłość regeneracji skóry

Komórki Macierzyste w Chirurgii Plastycznej: Rewolucja czy Zagrożenie?
Współczesna medycyna estetyczna i chirurgia plastyczna przechodzą dynamiczny rozwój dzięki zastosowaniu komórek macierzystych. Technologia ta, początkowo stosowana w regeneracyjnych terapiach medycznych, zyskuje na popularności jako rewolucyjna metoda poprawy wyglądu oraz regeneracji tkanek. Jednak rozwój tej technologii budzi zarówno entuzjazm, jak i kontrowersje etyczne oraz bezpieczeństwa. W tym artykule przeanalizujemy, czym są komórki macierzyste, jakie mają zastosowanie w chirurgii plastycznej oraz jakie wyzwania i zagrożenia są z nimi związane.
Czym są komórki macierzyste?
Komórki macierzyste to pierwotne komórki o zdolności do samoodnawiania się oraz różnicowania w różne typy komórek. Ich unikalna cecha polega na możliwości przekształcenia się w wyspecjalizowane komórki, takie jak komórki mięśniowe, nerwowe czy tłuszczowe. Dzięki tym właściwościom stanowią one fundament wielu innowacyjnych terapii medycznych.
Typy komórek macierzystych
- Komórki embrionalne (ESC) – uzyskiwane z wczesnych zarodków, mają największy potencjał różnicowania, ale budzą kontrowersje etyczne.
- Komórki somatyczne (dorosłe) – obecne w tkankach organizmu, takich jak szpik kostny czy tkanka tłuszczowa; ich potencjał jest bardziej ograniczony.
- Indukowane pluripotentne komórki macierzyste (iPSC) – sztucznie przekształcone komórki dorosłe, które zachowują właściwości pluripotencji.
Komórki macierzyste w chirurgii plastycznej, najczęściej pozyskiwane z tkanki tłuszczowej (ang. adipose-derived stem cells, ADSC), są łatwo dostępne dzięki procedurom liposukcji.
komórKI macierzyste w chirurgii plastycznej – zastosowanie
1. Regeneracja skóry i odmładzanie
Komórki macierzyste w chirurgii plastycznej są szeroko stosowane w terapiach odmładzających, ponieważ ich zdolność do stymulacji regeneracji skóry, produkcji kolagenu i elastyny sprawia, że są skuteczne w leczeniu zmarszczek, przebarwień oraz utraty elastyczności skóry.
Co więcej, badania naukowe: W badaniu przeprowadzonym przez Kim i in. (2017) oceniano efekty terapii ADSC na zmarszczki i jakość skóry u pacjentów. Wyniki wykazały znaczną poprawę nawilżenia skóry, redukcję zmarszczek oraz zwiększoną elastyczność skóry po 12 tygodniach leczenia.
2. Rekonstrukcja tkanek
W chirurgii plastycznej rekonstrukcyjnej komórki macierzyste są wykorzystywane do odbudowy uszkodzonych tkanek po urazach, oparzeniach czy zabiegach mastektomii. ADSC stosuje się do wzmacniania przeszczepów tłuszczu, co pozwala na lepsze utrzymanie objętości i poprawę ukrwienia przeszczepionych obszarów.
Przykłady kliniczne:
- Rekonstrukcja piersi: Komórki macierzyste są używane do regeneracji tkanek po mastektomii. Badania przeprowadzone przez Gentile i in. (2019) wykazały, że przeszczepy tłuszczu wzbogacone ADSC były bardziej stabilne i estetyczne niż tradycyjne przeszczepy tłuszczu.
- Leczenie blizn: ADSC skutecznie redukują widoczność blizn dzięki stymulacji produkcji kolagenu i poprawie ukrwienia skóry.
3. Przeszczepy tłuszczu
Przeszczepy tłuszczu wzbogacone ADSC są coraz bardziej popularne w zabiegach powiększania piersi, pośladków czy wypełniania zmarszczek, ponieważ ADSC poprawiają przetrwanie przeszczepionych komórek tłuszczowych, co przekłada się na dłuższe utrzymanie efektów zabiegu.
Mechanizmy działania komórek macierzystych
Komórki macierzyste wpływają na regenerację tkanek poprzez kilka mechanizmów:
- Wydzielanie czynników wzrostu: ADSC wydzielają cytokiny i czynniki wzrostu, takie jak VEGF (czynnik wzrostu śródbłonka naczyniowego), które stymulują regenerację naczyń krwionośnych.
- Różnicowanie w wyspecjalizowane komórki: Komórki macierzyste mogą przekształcać się w fibroblasty, adipocyty czy komórki nabłonkowe, dzięki czemu skutecznie wspomagają regenerację tkanek oraz odbudowę uszkodzonych struktur organizmu.
- Immunomodulacja: ADSC redukują stany zapalne, a tym samym wspomagają szybsze gojenie się ran i regenerację uszkodzonych tkanek.
Zalety stosowania komórek macierzystych
- Naturalność: Komórki macierzyste są pozyskiwane z organizmu pacjenta, dzięki czemu minimalizowane jest ryzyko odrzutu immunologicznego oraz zwiększa się bezpieczeństwo ich zastosowania w terapii.
- Wszechstronność: Mogą być stosowane w szerokim zakresie procedur, od odmładzania po rekonstrukcję tkanek.
- Długotrwałe efekty: Przeszczepy tłuszczu wzbogacone ADSC utrzymują się dłużej niż tradycyjne procedury.
Kontrowersje i zagrożenia
1. Etyczne dylematy
Zastosowanie komórek macierzystych, szczególnie embrionalnych, budzi wiele kontrowersji etycznych. Jednak wykorzystywanie zarodków ludzkich w celach badawczych czy terapeutycznych jest kwestią sporną w wielu krajach, co ogranicza możliwości badań i zastosowań klinicznych.
2. Bezpieczeństwo
Chociaż komórkom macierzystym przypisuje się ogromny potencjał, ich stosowanie wiąże się z pewnym ryzykiem. Wskazuje się, że ADSC mogą być odpowiedzialne za stymulowanie wzrostu komórek nowotworowych w organizmie, zwłaszcza gdy są aplikowane w obszarach z istniejącymi zmianami przednowotworowymi.
Przypadek kliniczny: W badaniu przeprowadzonym przez Thirabanjasak i in. (2010) zaobserwowano rozwój guzów w miejscach wstrzyknięcia ADSC, co miało miejsce u pacjentów, z wcześniej błędnie zdiagnozowanymi zmianami nowotworowymi.
3. Standaryzacja i kontrola jakości
Brak jednolitych protokołów dotyczących izolacji, przechowywania i aplikacji komórek macierzystych znacząco utrudnia zarówno ocenę ich skuteczności, jak i bezpieczeństwa. Co więcej, istnieje ryzyko, że komórki zostaną nieprawidłowo przygotowane, co w konsekwencji może prowadzić do powikłań i zwiększenia obaw związanych z ich stosowaniem.
Przyszłość komórek macierzystych w chirurgii plastycznej
1. Rozwój technologii i inżynierii tkankowej
Postęp w bioinżynierii otwiera nowe możliwości w tworzeniu spersonalizowanych terapii. Dlatego też naukowcy wykorzystują drukowanie 3D z komórkami macierzystymi do produkcji sztucznych tkanek i narządów, które znajdują zastosowanie w chirurgii plastycznej.
2. Personalizacja terapii
Analiza genetyczna pacjentów pozwala na lepsze dopasowanie terapii do ich indywidualnych potrzeb, co zwiększa skuteczność zabiegów.
3. Integracja z nanotechnologią
Połączenie komórek macierzystych z nanocząstkami może zwiększyć precyzję terapii, umożliwiając kontrolowane dostarczanie czynników wzrostu w miejsce uszkodzeń.
Wnioski
Komórki macierzyste stanowią jedno z najbardziej obiecujących narzędzi w chirurgii plastycznej, oferując szerokie możliwości regeneracji tkanek i poprawy wyglądu. Choć technologia ta wciąż znajduje się na wczesnym etapie rozwoju, jej potencjał jest ogromny. Niemniej jednak konieczne jest dokładne zbadanie ryzyk oraz opracowanie standardów bezpieczeństwa, aby w pełni wykorzystać jej zalety. Przyszłość medycyny estetycznej i rozwój terapii opartych na komórkach macierzystych może silnie kształtować przyszłość medycyny estetycznej, jednak ich powszechne zastosowanie wymaga dalszych badań oraz głębszej refleksji etycznej.
Przypisy:
- Kim, W. S., et al. (2017). Clinical application of adipose-derived stem cells in plastic surgery. Plastic and Reconstructive Surgery.
- Gentile, P., et al. (2019). The use of adipose-derived stem cells in breast reconstruction: A systematic review. Aesthetic Surgery Journal.
- Thirabanjasak, D., et al. (2010). Tumorigenicity of human mesenchymal stem cells injected into immunodeficient mice. Stem Cells and Development.
- Davidson, R. J., & McEwen, B. S. (2012). Social influences on neuroplasticity: Stress and interventions to promote well-being. Nature Neuroscience.
- Feusner, J. D., et al. (2010). Functional neuroimaging of body dysmorphic disorder. Neuropsychopharmacology.





























